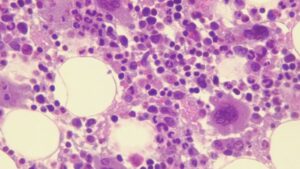

Noticias publicadas el 27 de septiembre de 2024
El Fibwi Palma ha puesto punto y final a su pretemporada con una solvente victoria en el Palau Municipal d’Esports d’Inca, donde los palmesanos se han impuesto este viernes por la noche al Bàsquet Ciutat d’Inca (61-104). 77
La Policía Nacional investiga las causas de la muerte de un ciudadano británico fallecido en la tarde de este viernes mientras jugaba al golf en el campo de Son Muntaner de Palma. 220
El sábado pasado, en el marco de la Nit de l’ Art, el escultor Jaume Plensa, Premio nacional de Artes plásticas y Premio Velázquez, presentó en la Llotja de Palma la exposición ‘Mirall’, dos de sus creaciones, ‘Invisible Laura’ e ‘Invisible Rui’. El espacio elegido presenta una singularidad muy específica. Creado ‘para el comercio’, lo […]
El Palmer Basket Mallorca Palma ha perdido este viernes por la tarde en Ibiza ante el Class Basquet Sant Antoni Palmer (72-67) en el cuarto y último partido de un Trofeu AON Illes Balears que este año ha estrenado un nuevo formato de competición. 47
El RCD Mallorca dormirá este viernes en posición de Champions League tras encadenar su tercera victoria consecutiva. Los de rojo y negro se han impuesto en el José Zorrilla al Real Valladolid (1-2) gracias a las dianas de Larin y Valery que han dejado en anécdota el postrero tanto de Iván Sánchez. 244
Hay que ir con cuidado en las cenas de matrimonios. Un comentario desafortunado, una indiscreción en voz alta, y se puede desatar una crisis conyugal de alcance desconocido. A veces la cosa no llega a tanto y se salda con una patada en la espinilla por debajo de la mesa. Si la coz es suficientemente […]
Los socorristas han sacado del agua a un bañista alemán de 64 años que ha sufrido un episodio de ahogamiento en la Playa de Cala Millor mientras que un niño de tres años ha sido rescatado de una piscina en la Playa de Alcúdia. Además, otras dos personas han sido atendidas y hospitalizadas este viernes […]
Tal y como ya hicimos el pasado año, en mallorcadiario.com aprovecharemos este mes de octubre para relatar algunas de las leyendas misteriosas de nuestra isla que se han ido transmitiendo de generación en generación. Después de viajar en el tiempo con la Dama Blanca hasta el milagro de ‘sa boira’ de Capdepera, pasando por los […]
El trasplante de médula ósea es, a veces, la única opción de tratamiento para determinadas patologías. De acuerdo con la fundación Josep Carreras, consiste mayoritariamente en sustituir las células enfermas del paciente por otras sanas de un donante. 61
«Madre de niña con autismo a Tucker Carlson: ‘mi hija nació sana; recibió una vacuna a los 7 meses y a los 10 meses era una niña diferente’. Se estima que 1 de cada 59 nacimientos en España son diagnosticados de TEA. ¿Por qué no es progresista hablar del orígen de esta pandemia?» (sic). Este […]
“Diferenciarse y crear valor desde el territorio”. Con esta sencilla frase, el decano del Colegio de Ingenieros Agrónomos de Levante, Joaquim Aguilella, ha definido el Trabajo de Fin de Máster con el que la mallorquina Laura Coll Ferragut, egresada del Máster en Ingeniería Agronómica de la UIB, ha conseguido el Premio Excelencia Novel. Lo ha […]
La Mostra Calvià es un evento gastronómico que organizamos desde la Fundación Calvià, con la colaboración del Ajuntament de Calvià con la intención de promocionar el sector de la restauración del término y posicionar Calvià como referente para el turismo gastronómico. Se celebra dos veces al año, los fines de semana de los meses de […]